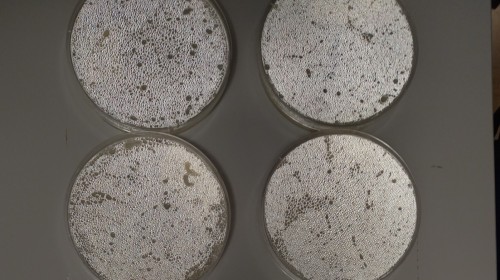

MOBILNOŚĆ NAUCZYCIELI-KURS EKOLOGICZNY "HOW TO SAVE THE WORLD" DZIEŃ 1

W poniedziałek 30 czerwca 2025 roku trójka nauczycieli z naszej szkoły rozpoczęła kurs ekologiczny "How to save the world".
Po sesji powitalnej uczestnicy mieli okazję nawiązać pierwsze kontakty z innymi uczestnikami kursu m.in. z Niemiec, Słowacji, Czech i Rumunii.
Kolejna część pierwszego dnia kursu stanowiła połączenie informacji teoretycznych z praktyką-uczestnicy zapoczątkowali dwa eksperymenty, których rezultaty widoczne będą na koniec kursu.
Zakończeniem pierwszego dnia było ćwiczenie "escape room" w czasie którego uczestnicy podsumowali zdobytą wiedzę.